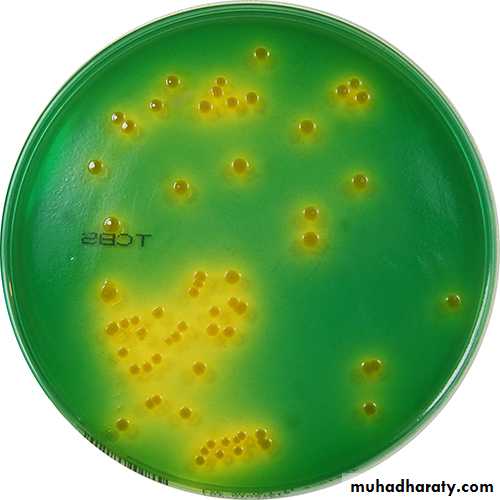
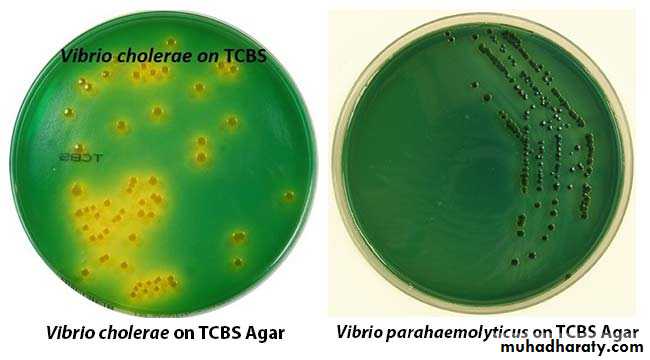

Vibrio cholerae
Mohammed Ameer
• Gram negative, curved, comma shaped bacilli.• Motile by single polar flagellum.
• Non spore forming.
• Non capsulated.
• Stain with dilute carbol-fuchsin.
Microscopical Appearance:
• Most vibrios have simple growth factor requirements and grow well in alkaline pH .
• Alkaline peptone water (enriched media for vibrio).• Thiosulfate-Citrate-Bile salt-Sucrose(TCBS)agar is the selective media for vibrio.
• NLF.
• Acid without gas is formed in Glucose ,Maltose,Manitol and sucrose fermentation .
• Facultative anaerobes
• Oxidase and catalase positive
• IMViC : +-v+
Culture Characteristics
TCBS medium is selective becauseAlso, contains bile salts.
High conc. of thiosulfate and citrate .
It contains sucrose.
It contains bromothymol blue.
Some species ferment sucrose & others not ferment
Sucrose fermenting Vibrio spp (V. cholerae) appears as
yellow colonies.
Sucrose non fermenting Vibrio spp (V. parahemolyticus)
appears as green colonies.
Identification of V. cholerae Growth on TCBS
Principle
Yellow colonies,
surrounded by a yellow zone